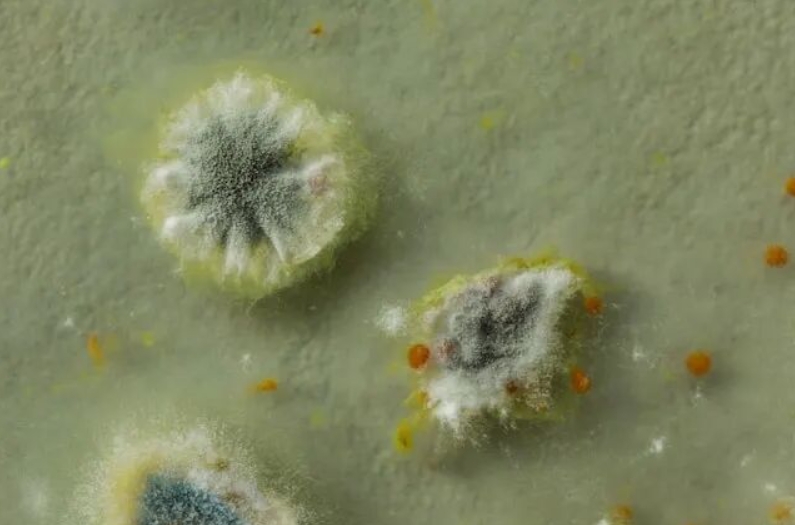
体内这种蛋白较低，容易遭受毛霉感染

图片来源:Unsplash+
2021年初,印度遭遇了一种更致命的疾病:毛霉菌病。这是一种真菌感染,会导致皮肤变黑,有数万名患者感染,死亡率高达50%。毛霉菌病由毛霉菌属真菌的孢子引起,这些孢子可通过吸入或伤口进入人体。这种真菌病源体分泌的毒素会杀死周围组织,使其变黑,有时只需数小时即可完成。据《科学》新闻(Science news)消息,一项新发表于《自然》(Nature)的研究将有助于识别毛霉菌病高危人群,并可能为治疗提供线索。
在该研究中,研究人员发现当从健康个体的血液样本中去除白蛋白后,毛霉菌便大量繁殖。在人体内,白蛋白能够运输多种分子并帮助维持血管渗透压的蛋白质。临床分析表明,低白蛋白水平可以预示着毛霉菌病患者的预后不良。研究人员发现相比于普通小鼠,经过基因改造后无法产生白蛋白的小鼠会比普通小鼠更容易感染毛霉菌,而其他真菌感染并没有差异。不过,当研究人员给这些基因敲除的小鼠注射白蛋白后,它们对感染的抵抗力显著增强。研究显示,游离脂肪酸是关键因素,这些小分子与白蛋白结合,防止其被氧化,从而使其能够进入真菌体内,阻断其内部激活生长,产生有害毒素的基因。而这似乎是人体对抗这些真菌的主要防线之一。一旦真菌开始生长,它们几乎可以绕过所有免疫反应。已有研究显示,糖尿病患者的白蛋白上会结合很多糖基,这会阻止该蛋白和脂肪酸结合,并保护脂肪酸免受氧化。这或许能解释为何这类患者更易患毛霉菌病。













































